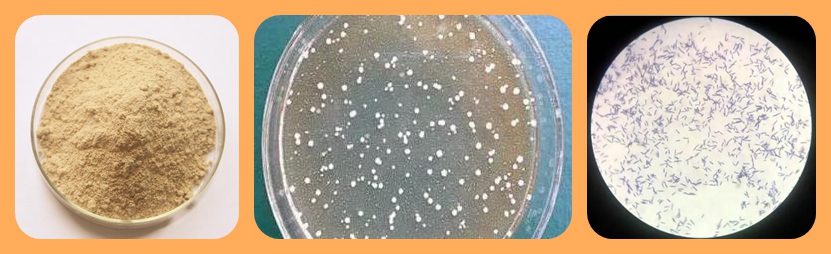

Introduction:
Bacillus coagulans belongs to the genus Bacillus in taxonomy, with rod-shaped cells, Gram positive bacteria, terminal spores, and no flagella.Specification:
Appearance
Light Brown powder
Odor
Slight fermented flavor
Content
Bacillus coagulans, carrier protectant
Activity
5Billion/g
10Billion/g
20Billion/g
Special customized
Purity
≥ 99.99% ( Impurity content: ≤100/g )
Humidity
≤ 8%
Mesh ( fineness )
Pure bacteria powder granule: 60 mesh
Characters
Acid and alkali resistant & High temperature resistance
High stability / Growth fast
Best PH: 6.6-7.0 ( can live in PH 1.0, but less activity)
Widely Use In
It is also can used for Food Industry / Medicine area etc.


Ms Wendy Lee
Mobile&Wechat&Whatsapp : 0086 13562692198
Email :yuedongbiotech@aliyun.com
Ms Jeff Wang
Mobile&Wechat&Whatsapp : 0086 13563622867
Email :wfyuedong@aliyun.com
Ms Sundy Lee
Mobile&Wechat&Whatsapp : 0086 15965090376
Email :yuedongsundy@aliyun.com


